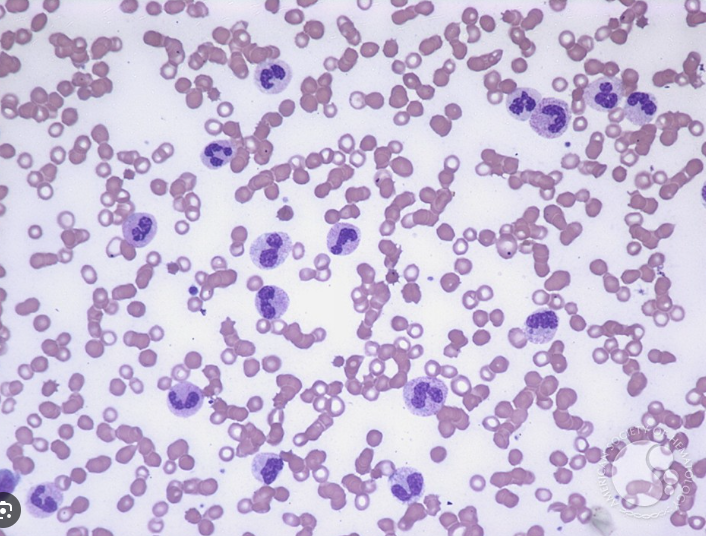

백혈구 수는 우리 몸의 면역 반응 상태를 보여주는 민감한 지표입니다.
감염, 염증, 약물, 스트레스 등 다양한 원인에 따라 증가 또는 감소할 수 있으며,
이러한 변화를 통해 임상적 단서를 얻을 수 있습니다.
이러한 백혈구, white blood cell, WBC 의 양적이상에 대한 내용입니다.
1. 호중구 증가증 (Neutrophilia)
호중구(Neutrophil)는 가장 흔한 백혈구 유형으로,
특히 급성 세균 감염에서 수치가 증가합니다.
급성 감염으로, 화농성 감염 (예: 농양, 폐렴, 패혈증 등)이 있는 경우 세균감염에 대응하여, 호중구가 증가합니다.
자가면역성 염증성 질환으로, 류마티스성 열(rheumatic fever), 류마티스 관절염, 결절성 동맥 주위염 등의
collagen vascular disease (CVD, 교원병)에서 주로 나타납니다.
기타, 급성 출혈, 급성 용혈 혹은, 혈관내 용혈,
스트레스 반응: 발작, 장기 구토, 탈수, 산증 등 에 의해서도 호중구 증가증이 나타날수 있습니다.
2. 호산구 증가증 (Eosinophilia)
호산구(Eosinophil)는 기생충 및 알레르기 반응에 관련된 백혈구입니다.


알레르기 질환으로, 습진, 천식(Asthma), 고초열(Hay fever), Loffler 증후군 등에서 호산구가 증가됩니다.
기생충 감염으로, 대부분의 장내 기생충 감염에서 동반 됩니다.
종양성 질환으로 Hodgkin 림프종, 만성 골수성 백혈병(CML)에서 증가할수 있씁니다.
그외, 과민성 장염, 궤양성 대장염 등의 질환에서도 증가될수 있습니다.
3. 호중구 감소증 (Neutropenia)
호중구 감소증은 감염 방어력 감소와 관련되며, 원인이 다양합니다.

선천성 호중구 감소증은, 앞서살펴본 질환들인,
유전성 호중구감소증, 체루악 증후군(Chediak-Higashi), 탈라세미아 등에서 발견됩니다.
약제 유발로 인한 호중구 감소증은,
Chlorpromazine, Propylthiouracil, Penicillin, Chloramphenicol, 항암제 등의 사용과 관련 있습니다
골수 억제 질환으로, 호중구 생성이 감소되는 경우는,
무관구증(Agranulocytosis), 재생불량성 빈혈, 백혈병, 거대적아구성 빈혈, Hypersplenism(비장기능 항진) 등이 가능합니다.
그외 전신감염에서도 호중구가 오히려 감소할수 있는데,
홍역, 돌발진, 풍진 등의 특정한 바이러스 감염, 이나 장티푸스, 말라리아와 같은 세균성 장염에서 오히려 호중구가 감소합니다.
4. 림프구 증가증 (Lymphocytosis)
림프구(Lymphocyte)는 주로 바이러스 감염과 관련이 깊습니다.


세균성 감염으로 백일해에서는 림프가 증가가 동반됩니다.
바이러스 감염으로, 전염성 단핵구증(EBV), CMV, Mumps, Rubella 등 각종 바이러스에 의해서 림프구가 증가됩니다.
소아기 생리적 상태에서도 호중구에 비해 상대적 림프구가 병적인 상황없이 정상적으로 우세할수 있으며,
결핵, 매독 등의 후반기 회복기 에서도 증가됩니다.
그외 구루병, 만성 저색소성 빈혈, 영양실조 등 의 영양장애 동반시에도 증가되며,
백혈병, 특히 급성 림프구성 백혈병(ALL) 등에서 림프구 증가가 동반됩니다.
이상으로, 백혈구(WBC)의 양적 이상 : 호중구 증가증 호중구감소증 림프구 증가 호산구증가입니다.
'소아 혈액질환' 카테고리의 다른 글
| 특발성 혈소판감소성 자반증 (ITP) 잦은멍, 점상출혈, 코피, 급성 만성 나이 (4) | 2025.08.05 |
|---|---|
| 출혈성 질환의 진단 : 혈소판수, Bleeding time (BT), PT 와 aPTT, 피브리노겐 측정 (2) | 2025.08.05 |
| 유전구형적혈구증 Hereditary Spherocytosis (HS) 치료 – 비정절제술 수혈, 엽산 보충, 철분보충 (2) | 2025.08.04 |
| 유전구형적혈구증 (Hereditary Spherocytosis, HS) - 유전구상적혈구증 원인 유전 증상 진단 (1) | 2025.08.01 |
댓글